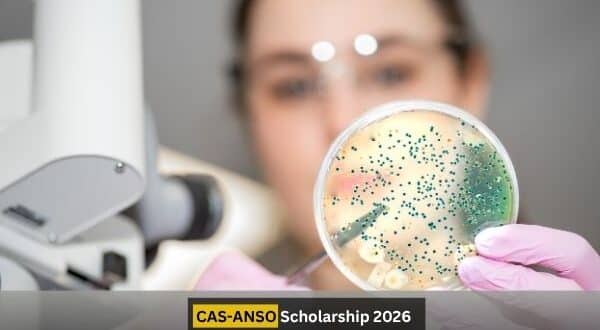
CAS-ANSO Scholarship 2026 in China

The ANSO Scholarship for Young Talents 2026 is one of China’s most prestigious fully funded opportunities offered by the Chinese Academy of Sciences (CAS) and the Alliance of International Science Organizations (ANSO). Designed to nurture future scientists and researchers from developing countries, this program provides international students the chance to pursue Master’s and PhD degrees at top Chinese universities, particularly at the University of Chinese Academy of Sciences (UCAS) and the University of Science and Technology of China (USTC).
With 100-200 Master’s and 40 PhD scholarships, ANSO promotes global collaboration and knowledge sharing. Students gain exposure to world-class laboratories, research mentors, and an international scientific community that encourages innovation in STEM, environmental science, biotechnology, and sustainable development.
This opportunity is globally admired because it removes financial barriers, provides cultural exposure, and builds research skills that align with the United Nations Sustainable Development Goals (SDGs).
About CAS and ANSO
The Chinese Academy of Sciences (CAS), ranked among the top 20 research institutions globally (Nature Index, 2025), is the national scientific think-tank of China. It leads major projects in science and technology and collaborates with over 100 international institutions.
The Alliance of International Science Organizations (ANSO) was established in 2018 to promote global cooperation in scientific research, technology innovation, and capacity building, particularly for developing nations. Its member institutions span 37 countries, making it a truly international initiative.
The ANSO-CAS collaboration aims to train future leaders in science and technology who can contribute to global sustainability.
Overview of CAS-ANSO Scholarship 2026
| Feature | Details |
| Scholarship Name | ANSO Scholarship for Young Talents 2026 |
| Host Institutions | University of Chinese Academy of Sciences (UCAS), University of Science and Technology of China (USTC) |
| Host Country | China |
| Degree Levels | Master’s and PhD |
| Scholarship Type | Fully Funded |
| Eligible Regions | All developing and Belt & Road countries |
| Duration | Master’s: up to 3 years • PhD: up to 4 years |
| Deadline | 31 January 2026 (Exact date to be announced) |
| Language of Instruction | English or Chinese |
Scholarship Benefits
Recipients of the CAS-ANSO Scholarship 2026 enjoy one of the most comprehensive financial packages in China:
- Full tuition waiver for the entire duration of study
- Monthly stipend:
– Master’s: RMB 3,000
– PhD: RMB 6,000–7,000 - Health insurance covering basic medical expenses
- Accommodation allowance or free university housing
- International round-trip airfare (one-time reimbursement)
- Visa application assistance and residence permit support
- Access to world-class laboratories and research supervision under CAS institutes
These benefits ensure students can focus solely on research without financial stress, promoting an ideal academic environment.
Eligibility Criteria
To qualify for the ANSO Scholarship 2026, applicants must meet the following requirements:
- Nationality: Must be a citizen of a developing country (non-Chinese).
- Education:
• Applicants for the Master’s program must hold a Bachelor’s degree.
• Applicants for the PhD program must hold a Master’s degree. - Academic Merit: Strong academic background in natural sciences, engineering, computer science, or related fields.
- Age Limit:
• Master’s: under 30 years old
• PhD: under 35 years old - Language: English or Chinese proficiency (TOEFL, IELTS, or medium of instruction certificate).
- Research Interest: Applicants must demonstrate a keen interest in research that aligns with CAS/ANSO’s global scientific goals.
- Commitment: Recipients are expected to return to their home country upon graduation and contribute to sustainable development.
Application Process
Follow these steps to successfully apply for the ANSO Scholarship 2026:
- Step 1: Visit the ANSO Scholarship portal and review eligibility requirements.
- Step 2: Choose your host university (UCAS or USTC) and preferred research field.
- Step 3: Prepare the required documents:
– Curriculum Vitae (CV)
– Academic transcripts and certificates
– Two recommendation letters
– Research proposal or study plan
– Passport copy
– English/Chinese proficiency certificate - Step 4: Complete the online application form on both ANSO and UCAS/USTC portals.
- Step 5: Submit before 31 January 2026. Late applications are not considered.
- Step 6: Shortlisted candidates may be invited for an interview by the selection committee.
Comparison of ANSO vs. Other Major Chinese Scholarships
| Scholarship Name | Funding Type | Degree Levels | Monthly Stipend (approx.) | Key Host Universities | Distinctive Feature |
| ANSO Scholarship (CAS) | Fully Funded | Master’s & PhD | RMB 3,000–7,000 | UCAS, USTC | Research focus under CAS institutes |
| CSC Scholarship | Fully Funded | Bachelor’s to PhD | RMB 3,000–3,500 | 250+ Chinese universities | Government-wide program |
| MOFCOM Scholarship | Fully Funded | Master’s | RMB 3,000 | Select universities under Ministry of Commerce | Development-oriented |
| Schwarzman Scholars | Fully Funded | Master’s (Global Affairs) | RMB 7,500 | Tsinghua University | Leadership & diplomacy focus |
Among all, the ANSO Scholarship stands out for its scientific research emphasis, higher stipend, and strong global collaboration network.
Why Apply for ANSO Scholarship 2026?
This scholarship represents more than financial aid—it’s a gateway to becoming part of a global scientific community. Students gain access to innovative projects, cutting-edge technology, and cross-cultural collaboration opportunities. Graduates often go on to work with UN agencies, global research institutions, and universities, promoting worldwide sustainability and technological progress.
FAQs About CAS-ANSO Scholarship 2026
- Can students from any country apply for the ANSO Scholarship?
Only students from developing and Belt & Road countries are eligible. - Is IELTS mandatory?
Not strictly. Proof of English proficiency or a medium of instruction certificate is sufficient. - Can I apply to both UCAS and USTC simultaneously?
Applicants should apply to one university only to avoid disqualification. - What is the duration of the scholarship?
Master’s: up to 3 years; PhD: up to 4 years. - Does the scholarship support the dependents?
No, the stipend covers only the student’s expenses. - Can applicants choose any research field?
Yes, within CAS-approved scientific disciplines. - Is there an age relaxation policy?
Generally, no exceptions are made beyond the specified age limits. - What if I graduate before the programme starts?
You must still meet the degree requirements at the time of enrollment. - Is this scholarship renewable annually?
Yes, renewal depends on academic performance and research progress. - What happens after completing the degree?
The program encourages graduates to return home and apply their knowledge to national or regional development.
If you’re passionate about research, sustainability, and scientific innovation, the CAS-ANSO Scholarship 2026 is your path to success. Start preparing your documents early and connect with your academic mentors for guidance. Don’t miss this opportunity to join a network of global changemakers shaping the future of science and technology. APPLY NOW.
Stay connected with us for the latest fully funded scholarships, internships, and fellowships from around the world. Subscribe to our updates so you never miss an opportunity that could transform your academic and professional journey.
 Opportunities Path Ultimate Guide to a Brighter Future
Opportunities Path Ultimate Guide to a Brighter Future